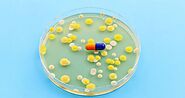
Antimicrobial Resistance: A Growing Threat and How to Combat It

-
About
- About Listly
- Community & Support
- Howto
- Chrome Extension
- Bookmarklet
- WordPress Plugin
- Listly Premium
- Privacy
- Terms
- DMCA Copyright
- © 2010-2025 Boomy Labs


 Harmeet Singh
Harmeet Singh
Listly by Harmeet Singh
Apex Hospitals is a well-known chain of specialized hospitals led by experienced medical professionals with over 30 years of expertise. It is accredited by the National Accreditation Board for Hospitals (NABH), which ensures high healthcare standards. The hospital group offers exceptional medical services.
Source: https://www.apexhospitals.com/

Probiotics support gut health, relieve IBS, improve digestion, and boost immunity. Explore natural sources like curd, dosa, and buttermilk.

Why They’re a Warning Sign You Shouldn't Ignore discusses transient ischemic attacks (TIAs), commonly known as "mini-strokes." It explains that a TIA is caused by a temporary disruption of blood flow to the brain, leading to stroke-like symptoms that resolve quickly, often within minutes. The article emphasizes that TIAs are critical warning signs of potential full strokes and highlights the importance of early medical intervention and preventive care.

Spinal disc problems commonly cause back pain and can significantly affect your quality of life. Understanding the symptoms, causes, and available surgical solutions is vital

Why Regular Prostate Exams Are Crucial for Men's Health emphasizes the importance of regular prostate exams to detect early signs of prostate cancer, which can lead to better outcomes if caught early. It also highlights the role of prostate screenings in maintaining overall men’s health, especially as they age. Proactive health measures like these can prevent serious conditions and improve quality of life.

Women and Heart Attacks explains that while heart attacks affect both men and women, women often experience different and more subtle symptoms. These can include fatigue, nausea, or jaw and back pain, making it harder to detect and diagnose heart attacks early. It emphasizes the importance of recognizing these unique signs for timely intervention and treatment to prevent complications.

Managing Chronic Kidney Disease explains the significance of early diagnosis and managing kidney disease through lifestyle changes, medications, and regular monitoring. It focuses on controlling underlying conditions such as diabetes and hypertension, which can prevent the progression of kidney disease and reduce complications. The blog also stresses the importance of a healthy diet and hydration for kidney function.

What is High Cholesterol? Causes and Risks explains the importance of managing cholesterol levels to maintain cardiovascular health. It outlines how high cholesterol can lead to the buildup of plaque in arteries, increasing the risk of heart disease and strokes. The article covers the causes, risks, and preventive measures to manage cholesterol levels through lifestyle changes and medication.

How to Spot Diabetes Early emphasizes the importance of recognizing early signs of diabetes to prevent complications. It covers symptoms such as frequent urination, excessive thirst, fatigue, and blurred vision, which may indicate elevated blood sugar levels. Early detection through regular check-ups and lifestyle changes is crucial in managing and preventing long-term effects of diabetes.
Antimicrobial Resistance: A Growing Threat discusses the increasing concern over antimicrobial resistance (AMR), where infections become harder to treat due to the overuse and misuse of antibiotics. It highlights how AMR is endangering global health and emphasizes the need for responsible antibiotic use, improved healthcare practices, and the development of new treatments to combat resistant infections.
